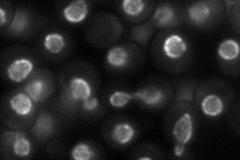
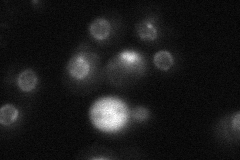
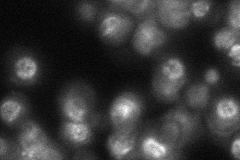
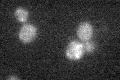

View description
Subunit of the nuclear pore complex (NPC), functions to anchor Nup2p to the NPC in a process controlled by the nucleoplasmic concentration of Gsp1p-GTP; potential Cdc28p substrate; involved in telomere maintenance
Localization:
Intensity:
Fold change:
Significance:
-
C’ GFP library in SD

below threshold16.23 -
N' NOP1pr-GFP in SD
punctate,nuclear periphery76.6489 -
N' TEF2pr-mCherry in SD
ER,vacuole15.9052 -
N' NATIVEpr-GFP in SD
punctate,nuclear periphery41.4703 -
N' TEF2pr-VC and Cyto-VN in SD

#N/A0 -
C’ GFP library in SD+DTT

cytosol14.40.88No -
C’ GFP library in SD+H2O2
cytosol17.341.06No -
C’ GFP library in Starvation Media

cytosol17.511.07No -
C’ GFP library on the background of Pup2-DaMP

N/A -
C’ GFP library on the background of CCT mutant

N/A0N/AYes
